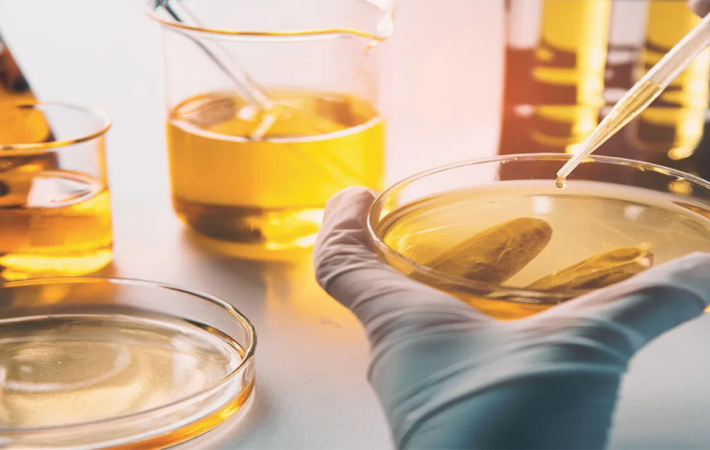
کیفیت-روغن-صنعتی

مقدمه
در نیروگاههای برقآبی، یاتاقانها از جمله قطعات کلیدی هستند که نقش اساسی در پایداری و عملکرد توربینها دارند. این قطعات در معرض نیروهای دینامیکی و فشار بالا قرار دارند و انتخاب روغن مناسب برای روانکاری آنها، یکی از مهمترین عوامل در افزایش عمر مفید و کاهش هزینههای نگهداری سیستم محسوب میشود.
روغن توربین با ویژگیهای خاصی که دارد، از سایش، خوردگی و دمای زیاد جلوگیری میکند و کمک میکند تا یاتاقانها در بهترین شرایط ممکن به فعالیت خود ادامه دهند. در این مقاله به طور کامل به بررسی ویژگیها، استانداردها، انواع و برندهای روغن توربین مناسب برای یاتاقانهای توربین برقآبی خواهیم پرداخت.
روغن توربین چیست و چه نقشی در عملکرد یاتاقانهای توربین دارد؟
روغن توربین یکی از مهمترین روانکارهای صنعتی در تجهیزات دوار مانند توربینهای گازی، بخار و برقآبی است. وظیفه اصلی این روغنها، روانکاری قطعات متحرک، انتقال حرارت، کاهش اصطکاک، و جلوگیری از زنگزدگی و سایش قطعات داخلی است.
در توربینهای برقآبی، یاتاقانها نقش بسیار حیاتی دارند زیرا محور اصلی توربین را نگه میدارند و تحمل بار و فشار زیادی را بر عهده دارند. اگر روغن مناسبی برای روانکاری آنها استفاده نشود، خیلی سریع دچار سایش، خرابی یا حتی گسیختگی میشوند.
این نوع روغن با ایجاد یک لایه نازک بین سطوح فلزی، اصطکاک را کاهش میدهد و از تماس مستقیم جلوگیری میکند. همچنین با خاصیت خنککنندگی خود، حرارت تولید شده در اثر اصطکاک را از محیط یاتاقانها دور میکند و دمای سیستم را در محدوده استاندارد نگه میدارد.
این خاصیت خنککنندگی بهویژه در توربینهایی که بهصورت ۲۴ ساعته کار میکنند، نقش بسیار مهمی دارد. همچنین این روغنها حاوی افزودنیهایی نظیر ضد اکسیداسیون، ضد سایش، ضد کف و ضد خوردگی هستند که باعث افزایش طول عمر سیستم میشوند.
افزودنیهای پاککننده نیز از تجمع رسوبات و لجن در مسیرهای روغنکاری جلوگیری میکنند. عدم وجود این افزودنیها ممکن است باعث گرفتگی فیلترها و مسیرهای روانکاری شود که در نهایت به آسیب جدی به یاتاقانها و توقف کار سیستم منجر خواهد شد.
در نتیجه، انتخاب یک روغن مناسب برای توربین با ویسکوزیته، افزودنیها و پایداری حرارتی مطلوب، نقش بسیار مهمی در تضمین عملکرد روان یاتاقانهای توربین برقآبی دارد. این انتخاب میتواند عمر مفید تجهیزات را افزایش دهد.

ویژگیهای ضروری یک روغن توربین یاتاقانهای برقآبی
روغن مورد استفاده در یاتاقانهای توربین برقآبی باید دارای ویژگیهای فنی خاصی باشد تا بتواند در شرایط کاری سخت و مداوم عملکرد مناسبی ارائه دهد. این ویژگیها نهتنها روی روانکاری تأثیر میگذارند بلکه نقش اساسی در خنککاری، محافظت از قطعات داخلی، کاهش مصرف انرژی و افزایش بهرهوری کلی سیستم دارند.
پایداری حرارتی بالا است
روغن توربین باید در برابر دمای بالا مقاومت کرده و دچار اکسیداسیون نشود. در غیر این صورت، بهسرعت خواص خود را از دست میدهد، لجن و رسوبات در سیستم ایجاد میشوند و کارایی یاتاقان کاهش مییابد.
ویسکوزیته مناسب است
ویسکوزیته نشاندهنده مقاومت روغن در برابر جریان است. اگر ویسکوزیته بیش از حد پایین باشد، فیلم روغن بین قطعات تشکیل نمیشود و اصطکاک افزایش مییابد. اگر بیش از حد بالا باشد، جریان روغن کند شده و سیستم دچار افت راندمان میشود.
مقاومت شیمیایی بالا
پایداری در برابر اکسیداسیون و مقاومت شیمیایی بالا در مواجهه با هوا، آب و فلزات است. روغنی که سریع اکسید شود، خاصیت روانکاری خود را از دست میدهد و منجر به ایجاد اسید و لجن در سیستم میشود.
خاصیت ضد زنگ
روغن مورد نظر همچنین باید دارای خاصیت ضد زنگ و ضد خوردگی باشد. در نیروگاههای برقآبی که رطوبت زیاد است، احتمال خوردگی فلزات داخلی سیستم بسیار بالاست. روغن باید بتواند از قطعات فلزی در برابر این عوامل محافظت کند.
در نهایت، روغن باید قابلیت جدا شدن از آب و قابلیت فیلتراسیون بالا داشته باشد تا بتواند آلودگیها، ذرات معلق و رطوبت را بهراحتی از سیستم جدا کند. در غیر این صورت، آلودگیها میتوانند باعث سایش زودهنگام قطعات و گرفتگی مسیرهای روانکاری شوند.
چرا انتخاب روغن توربین مناسب برای یاتاقانهای توربین آبی اهمیت دارد؟
اهمیت انتخاب صحیح روغن توربین برای یاتاقانهای توربین آبی را نمیتوان نادیده گرفت. این انتخاب نقش مستقیمی در طول عمر تجهیزات، کاهش هزینههای تعمیرات، بهرهوری سیستم و ایمنی کلی نیروگاه ایفا میکند. در یاتاقانهای توربین آبی، نیروها و فشارهای قابل توجهی در حال وارد شدن به سطح تماس فلزات هستند.
در چنین شرایطی، یک روغن باکیفیت برای توربین میتواند اصطکاک را به حداقل رسانده و از تماس مستقیم فلز با فلز جلوگیری کند. این موضوع مستقیماً از سایش زودهنگام و تولید حرارت غیرمجاز جلوگیری میکند. علاوه بر این، روغن نامناسب ممکن است دچار اکسیداسیون سریع شود که در نتیجه آن، اسید و رسوبات در سیستم شکل میگیرند.
این اتفاق باعث گرفتگی فیلترها، آسیب به پمپهای روغن و کاهش شدید راندمان روانکاری خواهد شد. همچنین ممکن است نیاز به تعویض زودهنگام روغن و افزایش هزینههای عملیاتی ایجاد شود. روغن مناسب باید در مقابل آلودگیها، رطوبت، فشار بالا و تغییرات دما مقاومت کند و ویژگیهای روانکاری خود را در طولانیمدت حفظ نماید.
این امر بهویژه در شرایطی که توربین بهصورت مداوم در حال کار است، اهمیت دوچندان دارد. از سوی دیگر، عملکرد پایدار یاتاقانها مستقیماً بر کارکرد کلی نیروگاه و تولید برق مؤثر است. خرابی یک یاتاقان ممکن است منجر به توقف کامل توربین شود که خسارات مالی و زمانی زیادی به همراه دارد.
انتخاب روغن مناسب میتواند از این اتفاق جلوگیری کرده و به بهرهبرداری بهینه از توربین کمک کند. در نهایت، استفاده از روغن با مشخصات دقیق و سازگار با تجهیزات، بر اساس توصیههای سازنده توربین و تطابق با استانداردهای بینالمللی، تضمینکننده سلامت و عملکرد پایدار یاتاقانهای توربین آبی خواهد بود.
استانداردهای بینالمللی مرتبط با روغن توربین برای یاتاقانهای توربین برقآبی
یکی از مهمترین مراحل در انتخاب روغن توربین، توجه به استانداردهای بینالمللی است. این استانداردها، کیفیت روغن را تضمین کرده و باعث میشوند که روغن در شرایط مختلف محیطی و عملیاتی عملکرد قابل اعتمادی داشته باشد. استانداردهای ISO، DIN، ASTM و API شناختهشدهترین معیارها برای این نوع روغن ها هستند.
استاندارد ISO VG (Viscosity Grade)
یکی از مهمترین شاخصها است که ویسکوزیته روغن را در دمای ۴۰ درجه سانتیگراد تعیین میکند. ویسکوزیته باید متناسب با شرایط کاری یاتاقان انتخاب شود تا هم روانکاری مناسبی انجام شود و هم از مصرف انرژی اضافی جلوگیری گردد. مثلاً برای یاتاقانهای بزرگتر، معمولاً روغنهایی با ویسکوزیته بالاتر استفاده میشوند.
استاندارد DIN 51515
مخصوص روغنهای توربین است که کیفیت، مقاومت در برابر اکسیداسیون، و خواص ضد خوردگی را تعریف میکند. روغنی که این استاندارد را داشته باشد، میتواند در شرایط سخت عملکرد خوبی ارائه دهد و طول عمر سیستم را افزایش دهد.
استاندارد ASTM D4378
این استاندارد مربوط به روغنهای توربین و روانکارهای صنعتی است که آزمونهای مختلفی مثل تست اکسیداسیون، ویسکوزیته، عدد اسیدی و میزان کفکردن روغن را شامل میشود. رعایت این استاندارد باعث میشود که روغن در برابر تغییرات محیطی و عملیاتی مقاوم باشد.
استفاده از روغنهایی که استانداردهای بینالمللی معتبر دارند، تضمین میکند که این محصولات از نظر کیفیت و عملکرد مطابق با نیازهای یاتاقانهای توربین برقآبی ساخته شدهاند. همچنین سازندگان توربینها معمولا در دفترچههای فنی خود به این استانداردها اشاره میکنند و توصیه میکنند که حتماً روغن مطابق با آنها انتخاب شود.
انواع روغن توربین مناسب برای یاتاقانهای توربین برقآبی
روغنهای توربین بر اساس نوع پایه و ترکیبات افزودنی به سه دسته اصلی تقسیم میشوند: روغنهای معدنی، روغنهای سنتتیک و روغنهای نیمهسنتتیک. انتخاب نوع روغن مناسب باید بر اساس شرایط کاری، دمای محیط، و مشخصات فنی توربین صورت گیرد.
روغنهای معدنی از نفت خام به دست میآیند و نسبت به دیگر انواع، قیمت پایینتری دارند. این روغنها معمولاً در شرایط کاری معمولی و دماهای پایینتر استفاده میشوند. اما محدودیتهایی در پایداری حرارتی و مقاومت در برابر اکسیداسیون دارند که باعث میشود برای توربینهای با بار کاری سنگین مناسب نباشند.
روغنهای سنتتیک از مواد شیمیایی ساخته شده و در برابر دماهای بالا و شرایط سخت کاری مقاومت بیشتری دارند. این روغنها ویسکوزیته پایدارتر و عمر طولانیتری نسبت به روغنهای معدنی دارند. همچنین مقاومت بالایی در برابر اکسیداسیون، خوردگی و تشکیل رسوبات دارند که برای یاتاقانهای توربین آبی بسیار مهم است.
روغنهای نیمهسنتتیک ترکیبی از روغنهای معدنی و سنتتیک هستند که تلاش میکنند تعادل خوبی بین هزینه و کارایی ایجاد کنند. این روغنها برای توربینهایی که نیاز به کارکرد متوسط تا سنگین دارند مناسباند و میتوانند عملکرد قابل قبولی ارائه دهند.
در نهایت، برخی از نیروگاهها به دلایل زیستمحیطی و مقررات خاص، از روغنهای زیستتخریبپذیر استفاده میکنند که پایه گیاهی دارند و در صورت نشت، آلودگی کمتری ایجاد میکنند. البته این نوع روغنها ممکن است هزینه بالاتری داشته باشند و نیاز به نگهداری دقیقتری دارند.
عوامل مؤثر در طول عمر روغن توربین
طول عمر روغن توربین تحت تأثیر عوامل مختلفی قرار دارد که شناخت و مدیریت آنها میتواند هزینههای نگهداری را کاهش داده و عملکرد یاتاقانها را بهبود بخشد. در ادامه به مهمترین این عوامل و روشهای افزایش دوام روغن اشاره میکنیم.
اولین و مهمترین عامل، کیفیت اولیه روغن است. استفاده از روغنهای با استاندارد بالا و برند معتبر میتواند باعث شود که روغن مدت بیشتری در شرایط بهینه باقی بماند. همچنین اضافه کردن افزودنیهای مناسب میتواند ویژگیهای ضد اکسیداسیون و ضد خوردگی را تقویت کند.
عامل دوم، شرایط عملیاتی توربین است. افزایش دما، وجود رطوبت زیاد، آلودگی هوا و فشار بالا میتواند باعث کاهش عمر روغن شود. به همین دلیل باید شرایط محیطی و عملیاتی به دقت کنترل شود تا روغن کمتر تحت تأثیر عوامل مخرب قرار گیرد.
عامل سوم، برنامه نگهداری و آنالیز دورهای روغن است. نمونهگیری منظم و آزمایش پارامترهایی مانند ویسکوزیته، عدد اسیدی، مقدار فلزات سایشی و میزان رطوبت، به پیشبینی زمان تعویض یا اصلاح روغن کمک میکند. این کار از بروز خرابیهای ناگهانی جلوگیری میکند.
از جمله روشهای افزایش دوام روغن، استفاده از سیستمهای فیلتراسیون پیشرفته و سنسورهای پایش کیفیت روغن است که به طور مداوم آلودگیها را حذف و شرایط روغن را بهینه نگه میدارند. در نهایت، تعویض به موقع روغن طبق توصیه سازنده توربین و پاکسازی کامل مخازن و مسیرهای روغنکاری نیز از اهمیت زیادی برخوردار است.
بهترین برندها و محصولات روغن توربین برای یاتاقانهای توربین آبی
در بازار جهانی، برندهای معتبر و شناختهشدهای وجود دارند که روغنهای توربین با کیفیت بالا تولید میکنند و هر کدام ویژگیهای خاصی دارند. انتخاب برند مناسب میتواند تفاوت قابل توجهی در عملکرد و طول عمر یاتاقانها ایجاد کند.
برند Shell یکی از پیشروهای صنعت روانکارها است و محصولاتی مانند Shell Turbo T و Shell Turbo S را ارائه میدهد. این روغنها به دلیل پایداری حرارتی بالا، مقاومت در برابر اکسیداسیون و خاصیت ضد خوردگی شناخته شدهاند و در بسیاری از نیروگاههای برقآبی استفاده میشوند.
Mobil با محصولات Mobil DTE 832 و Mobil SHC 918 نیز در بازار بسیار محبوب است. این روغنها افزودنیهای پیشرفتهای دارند که عملکرد روانکاری طولانیمدت و مقاومت بالایی در برابر رطوبت و آلودگی ارائه میدهند.
Total و BP نیز برندهایی هستند که محصولات با کیفیت و مورد تأیید بینالمللی ارائه میکنند و در نیروگاههای مختلف جهان به کار گرفته میشوند. در انتخاب برند، بهتر است به تأییدیههای فنی، استانداردهای بینالمللی، و نظرات سازنده تجهیزات توجه شود. همچنین خرید از نمایندگیهای رسمی باعث اطمینان از اصالت و کیفیت روغن میشود.
نحوه نگهداری و تعویض روغن توربین در سیستم یاتاقان نیروگاههای برقآبی
نگهداری صحیح روغن توربین به اندازه انتخاب روغن اهمیت دارد. با رعایت نکات مربوط به نگهداری، میتوان عمر مفید روغن و یاتاقانها را افزایش داد و از خرابیهای ناگهانی جلوگیری کرد. اولین قدم در نگهداری، انجام آزمایشهای دورهای روی نمونههای روغن است.
این آزمایشها پارامترهایی مانند ویسکوزیته، عدد اسیدی، میزان رطوبت و فلزات سایشی را بررسی میکنند. نتایج این آزمایشها کمک میکند تا زمان تعویض یا تصفیه روغن مشخص شود. دومین نکته، مراقبت از فیلترهای سیستم است.
فیلترها باید به طور منظم تمیز یا تعویض شوند تا جریان روغن بدون مشکل ادامه یابد و روغن به خوبی روانکاری کند. استفاده از سیستمهای فیلتراسیون آنلاین یا آفلاین نیز میتواند باعث افزایش عمر روغن شود. این سیستمها به طور مداوم ذرات معلق و آلودگیها را از روغن حذف میکنند.
در زمان تعویض روغن، باید دقت کرد که مخازن و خطوط لوله کاملاً تمیز باشند تا روغن جدید آلوده نشود. همچنین ترکیب روغن جدید و قدیمی معمولاً توصیه نمیشود چون خواص روغن را تغییر میدهد.
راهنمای نهایی انتخاب روغن توربین برای افزایش عمر یاتاقانهای توربین آبی
انتخاب روغن توربین مناسب برای یاتاقانهای توربین برقآبی یکی از کلیدیترین عوامل در تضمین عملکرد پایدار و اقتصادی این تجهیزات است. روغن علاوه بر روانکاری، وظایف خنککنندگی، محافظت در برابر خوردگی و پاکسازی را بر عهده دارد.
ویژگیهای کلیدی شامل پایداری حرارتی، ویسکوزیته مناسب، مقاومت در برابر اکسیداسیون و خاصیت ضد خوردگی است که باید به دقت مد نظر قرار گیرد. همچنین انتخاب نوع روغن بر اساس شرایط محیطی و فنی بسیار مهم است.
رعایت استانداردهای بینالمللی و استفاده از برندهای معتبر، به تضمین کیفیت و عملکرد کمک میکند. همچنین برنامه منظم نگهداری و آنالیز روغن، کلید جلوگیری از خرابیهای ناگهانی است. در نهایت، روغن توربین باید به عنوان یکی از عناصر استراتژیک در بهرهوری نیروگاهها در نظر گرفته شود تا بتوان عملکرد بهینه یاتاقانها و کاهش هزینههای عملیاتی را تضمین کرد.

نظرتان را بگذارید
آدرس ایمیل شما منتشر نخواهد شد. فیلدهای الزامی علامت گذاری شده اند *